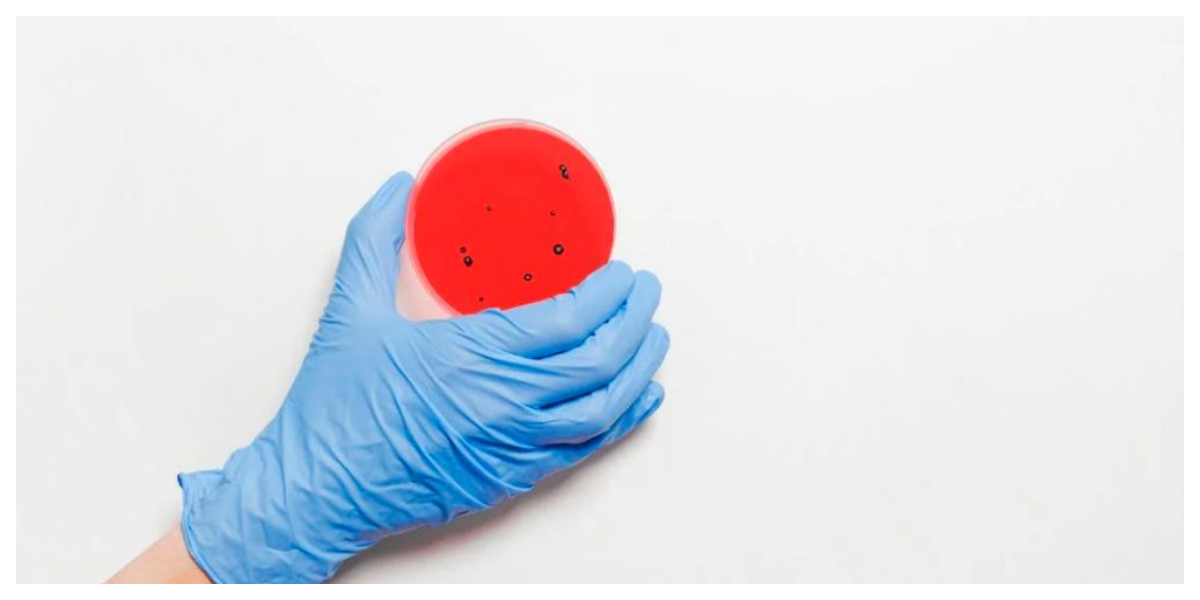

France, Germany, Belgium report first monkeypox cases
France, Belgium, and Germany On Friday, became the first European and North American countries to record cases of monkeypox, a disease that is widespread in areas of Africa. Monkeypox was discovered in a 29-year-old male in the Ile-de-France area, which includes Paris, who had not recently returned from a place where the virus was active, according … Read more